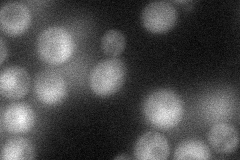
YGR170W
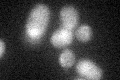
YGR170W

View description
Phosphatidylserine decarboxylase of the Golgi and vacuolar membranes, converts phosphatidylserine to phosphatidylethanolamine
Localization:
Intensity:
Fold change:
Significance:
-
C’ GFP library in SD

cytosol20.11 -
N' NOP1pr-GFP in SD
cytosol,nucleus42.8955 -
N' TEF2pr-mCherry in SD

nucleus20.2775 -
N' NATIVEpr-GFP in SD

below threshold20.0862 -
N' TEF2pr-VC and Cyto-VN in SD

below threshold23.4565 -
C’ GFP library in SD+DTT

cytosol20.050.99No -
C’ GFP library in SD+H2O2
cytosol23.911.18No -
C’ GFP library in Starvation Media

cytosol19.40.96No -
C’ GFP library on the background of Pup2-DaMP

cytosol -
C’ GFP library on the background of CCT mutant

cytosol20.51541.01937No
